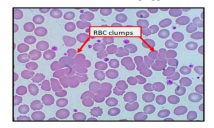

Healthcare
January 3, 2023
Impact of COVID-19 on Home Health-Care Sector in Saudi Arabia: A Systematic Review
Unified Nursing Research, Midwifery & Women’s Health Journal Volume 1, Issue 3, January 2023, Pages: 01-20 Received: October 13th, 2022,…
Nursing
March 20, 2025
Advancing Clinician’s Skills on Using EMR System
Unified Nursing Research, Midwifery & Women’s Health Journal Authors Names: Mr. Rami Alkhleitit, Dr. Yousef Alshrari, Mr. Khalid AlZahrani, Ms.…
Cancer
February 27, 2024
Prostein expression in human tumors: A tissue microarray study on 19,202 tumors
Presented in 13th Emirates Pathology, Digital Pathology & Cancer Conference Holiday Inn Dubai, UAE & Virtual Poster Presenter Name: Dr.…
Gastroenterology
March 2, 2024
Liver actinomycotic abscess a rare complication of gastro- oesophageal reflux disease-related mucosal injury
Presented in 13th World Gastroenterology, IBD & Hepatology Conference in Holiday Inn Dubai, Al Barsha, UAE & Virtual from December…
Nursing
August 1, 2024
Innovative Approaches and Best Practices in Dialysis Care in Global Settings
Speaker Name: Prof. Jaime A. Leongson She will present her oral presentation at the 14th International Healthcare, Hospital Management, Nursing,…
Cancer
September 18, 2025
Diagnostic Challenges of Emerging and Common High-Grade Endometrial Carcinoma Entities
Keywords: Endometrial carcinoma, FIGO grade 3, Pilomatrix-like high grade endometrial carcinoma Introduction: * The talk will include case presentations focusing…
Nursing
August 1, 2024
A study to assess the effectiveness of communication framework and positive work culture in enhancing patient experience.
Poster Presenters Name: Ms. Ligy Ranjith, Ms. Nisha M Paul, Ms. Sinimol Thomas They presented their poster presentation at the 14th…
Endocrinology
May 24, 2020
What are the effects of hostile environments on refugee and migrant children and young people accessing healthcare?
Unified Nursing Research, Midwifery & Women’s Health Journal Volume 1, Issue 1, June 2020, Pages: 61-70 Received: Mar. 5, 2020;…
Pathology
September 25, 2025
An Audit of Histopathological Reporting Standards in TURBT Specimens at Queen Elizabeth Hospital, London
Introduction: Background: Accurate histopathological reporting of Transurethral Resection of Bladder Tumour (TURBT) specimens is essential for guiding clinical decision-making, staging,…
Cancer
February 27, 2024
Patterns of estrogen receptor expression across 18,500 tumor samples obtained from 149 cancer types
Presented in 13th Emirates Pathology, Digital Pathology & Cancer Conference Holiday Inn Dubai, UAE & Virtual Poster Presenter Name: Dr.…
Cancer
June 6, 2021
Changes in ER, PR and HER2 Expression in Primary Breast Cancer, Lymph Nodes and Distant Metastases
Global Journal of Cancer Research and Treatment Volume 1, Issue 1, August 2020, Pages: 1-6 Received: August 20, 2020; Accepted:…
Pathology
September 26, 2025
Prognostic Factors in Low Rectal Cancer Patients Treated with Neoadjuvant Chemoradiation and Abdominoperineal Resection.
Keywords: low rectal cancer, abdominoperineal resection, neoadjuvant chemo radiation. Introduction: This study assessed the prognostic impact of key histopathological and…
Nursing
August 19, 2021
Collect One, Use Many: Getting Best Use from a Standardized Nursing Classification in the EP
Unified Nursing Research, Midwifery & Women’s Health Journal Volume 1, Issue 2, August 2021, Pages: 01-19 Received: July 16, 2021;…
Cancer
June 6, 2021
Current Developments in Breast Cancer
Global Journal of Cancer Research and Treatment Volume 1, Issue 2, August 2021, Pages: 14-20 Received: May 10, 2021; Accepted:…
Pathology
October 1, 2025
The Uncommon Mandibular Malignancy: A Case Of Fibrosarcoma with Favorable Surgical Outcome
Keywords: Fibrosarcoma, Mandible, Spindle Cell Sarcoma, Rare Case, Histopathology Introduction: Primary malignant tumors of the mandible are rare, and among…
Healthcare
November 28, 2023
It’s Time to Make Sleep a Vital Sign: Continuing Clinical Excellence through Evidence-based Practice
Unified Nursing Research, Midwifery & Women’s Health Journal Author: Dr. Ian J. Lynch Affiliation: Tripler Army Medical Center Category: Abstract…
Pathology
June 3, 2023
THE IMPACT OF COGNITIVE FLEXIBILITY ON NARRATIVE IN ALGERIAN APHASIC PATIENTS
Presented in 12th Emirates pathology, digital pathology Conference Holiday Inn Dubai, Al Barsha, UAE & Virtual Speaker Name: Prof. Nadia…
Nursing
October 1, 2024
TRANSFORMING HEALTHCARE: THE IMPACT OF AI
Presented in International Healthcare, Hospital Management, Nursing, and Patient Safety Conference Holiday Inn Dubai, UAE & Virtual Speaker Name: Dr Vibha Jain…
Pathology
February 3, 2022
Correlation of The Efficacy Of Convalscent Plasma In Covid – 19 Patients with The Titre Of IgG Antibodies In A Tertiary Care Setup
Global Journal of Pathology & Laboratory Medicine Volume 1, Issue 4, January 2022, Pages: 51-58 Received: November 20, 2021, Reviewed:…
Endocrinology
May 24, 2020
Preventing Healthcare Acquired Infections: Staff Education is Crucial
Unified Nursing Research, Midwifery & Women’s Health Journal Volume 1, Issue 1, June 2020, Pages: 70-78 Received: Mar. 17, 2020;…
Pharmaceuticals
September 26, 2025
UCG RELATED CONFERENCES
International Heart Health & Cardiac Surgery ConferenceDedicated to the latest research and innovations in cardiology and cardiac surgery.More Information &…
Pathology
October 3, 2025
Molecular and Immunohistochemical Profiling of Pediatric Brain Tumors in Uzbekistan
Keywords: pediatric neuro-oncology, Uzbekistan, brain tumor biomarkers, p53, H3K27M, IDH1 R132H, GFAP, immunohistochemistry, molecular pathology. Introduction: This preliminary investigation explores…
Cancer
March 2, 2024
Use of a rapid automated PCR assay to rescue failed RNA next generation sequencing for detection of gene fusion events in non-squamous, non-small cell neuroendocrine carcinoma (NSCLC) of the lung: a clinical, retrospective pilot verification study
Presented in Emirates Pathology, Digital Pathology & Cancer Conference Holiday Inn Dubai, UAE & Virtual Speaker Name: Dr. Alison Finall…
Pathology
September 26, 2025
Molecular and Clinicopathologic Analysis of Undifferentiated Carcinoma with Osteoclast-Like Giant Cells of the Pancreas: A Case Report Series
Keywords UC-OGC, pancreatic cancer, KRAS G12V, molecular pathology, histopathology Other authors: Gulrukh Botiralieva, Sayyora Shotmonova, Bakhriddin Babanov, Allayeva Kamilla Primary…
Healthcare
5 days ago
Heat Resilience and Safe Outdoor Play in UAE Children: A New Frontier for Community Health Promotion
Unified Nursing Research, Midwifery & Women’s Health Journal Authors Names: Dr. Rabab Gad Abd El-kader, Ms. Sneha Pitre Category: Abstract…
Pathology
August 23, 2021
Paget`s disease of the Breast. Differential diagnosis using additional IHC-panel. Literature review and own observations.
Global Journal of Pathology & Laboratory Medicine Volume 1, Issue 2, June 2021, Pages: 25-49 Received: July 11, 2021, Reviewed:…
Pathology
April 11, 2023
Cytohistopathological Correlation Of Thyroid Swellings, A Retrospective Study In A Tertiary Hospital
Global Journal of Pathology & Laboratory Medicine Volume 2, Issue 1, April, Pages: 1-25 Received: April 5, 2023 Reviewed: April…
Pathology
January 17, 2022
Assessing Platelet Count as a Confounding Factor In Covid-19 Positive Patients
Global Journal of Pathology & Laboratory Medicine Volume 1, Issue 4, January 2022, Pages: 58-64 Received: September 28, 2021, Reviewed:…
Pathology
April 11, 2023
Studying The Individual Role And Interrelationship Between Mean Platelet Volume And Platelet Distribution Width In Predicting The Fall/Rise Of Platelet Count In Dengue
Global Journal of Pathology & Laboratory Medicine Volume 2, Issue 1, July, 25-36 Received: April 5, 2023, Reviewed: April 7,…
Pathology
June 28, 2021
Glioblastoma with PNET- like Component- A Rare Case Report
Global Journal of Pathology & Laboratory Medicine Volume 1, Issue 2, June 2021, Pages: 15-19 Received: June 10, 2021; Reviewed:…
Pathology
June 6, 2021
Metastasis of Non-Pigmented Melanoma in the Breast – Case Report
Global Journal of Pathology & Laboratory Medicine Volume 1, Issue 2, August 2021, Pages: 14-20 Received: April 11, 2021; Accepted:…
Healthcare
August 3, 2023
Telehealth and Virtual Clinical Trials: The Interplay of Data Engineering and Cloud Technologies for a Digital-First Healthcare Approach Use
Unified Nursing Research, Midwifery & Women’s Health Journal Volume 2, Issue 1, August 2023 Received: July 20, 2023, Reviewed: July…
Healthcare
April 12, 2020
The Pathobiology and Clinical implications of Paraneoplastic Syndromes in patients with Neuroendocrine Neoplasia : Science, Basics and Updates
Global Journal of Diabetes, Endocrinology & Metabolic Disorders Volume 1, Issue 1, June 2020, Pages: 28-40 Received: Mar. 17, 2020;…
Cancer
April 22, 2024
Language Deficits in Amyotrophic Lateral Sclerosis
Presented in 14th Emirates Pathology, Digital Pathology & Cancer Conference Holiday Inn Dubai, UAE & Virtual Speaker Name: Prof. Nadia…
Healthcare
April 12, 2020
Electronic water can reduce oxidative stress in cancer and diabetes patients for 3 weeks drinking
Global Journal of Diabetes, Endocrinology & Metabolic Disorders Volume 1, Issue 1, June 2020, Pages: 20-28 Received: Mar. 17, 2020;…
Pathology
September 26, 2025
A Decade of Progress: A Literature Review of Artificial Intelligence Applications in Histopathology (2015–2025)
Keywords: Artificial intelligence; Histopathology; Deep learning; Cancer detection; Whole-slide imaging. Introduction: Between 2015 and 2025, artificial intelligence (AI) has significantly…
Pharmaceuticals
January 2, 2026
Artificial Intelligence Across the Drug Discovery Pipeline: From Molecule to Market
Name: Dr. Zahraa Khalifa Research interest: Advanced delivery systems, nanotechnology, vaccine adjuvants, drug discovery Presenting By: 17th Global Digital Pharma,…
Pathology
September 29, 2025
Utilization of Savi Scout Radar versus Wire-Guided Localization in Neoplastic Breast Lesions: A Retrospective Review Comparing Margin Status and Re-Excision Rates.
Introduction: Traditionally, neoplastic breast lesions have been localized pre-operatively for surgical excision using Wire-Guided Localization, in which lesions are tagged…
Cancer
March 2, 2024
Prevalence of BRAF V600E Mutation in the Iranian Patients with Hairy Cell Leukemia: A Retrospective Study
Presented in 13th Emirates Pathology, Digital Pathology & Cancer Conference Holiday Inn Dubai, UAE & Virtual Global Journal of Pathology…
Pathology
October 3, 2025
Cytological Diagnosis of Follicular Thyroid Lesions
Keywords: cytology diagnosis, follicular thyroid lesions. Introduction Over the past twenty years, the incidence of thyroid cancer in our country…
Pathology
September 22, 2025
Transforming Pediatric Tumour Pathology with Generative Language Models
Keywords: Pediatric Tumours, Generative AI, Pathology, Language Models, Retrieval-Augmented Generation Abstract: Generative Artificial Intelligence (AI), particularly large language models (LLMs),…
Healthcare
November 30, 2023
Ethical AI and the Future Of Healthcare: Combining Academic Theory And Industry Practice To Mitigate Patient Risk and Harm
Unified Nursing Research, Midwifery & Women’s Health Journal Author: Prof. Dillon Plummer Affiliation: Capitol Technology University Category: Abstract Unified Citation…
Nursing
January 13, 2023
Child Nutrition During the Pandemic: The Impact of Work-Status
Unified Nursing Research, Midwifery & Women’s Health Journal Volume 1, Issue 3, January 2023, Pages: 01-11 Received: October 5th, 2022,…
case report
August 20, 2025
Forensic Insights into a Traumatic Right-Hand Amputation in an 11-Year-Old Male Following Assault: A Case Report
Global Journal of Pathology & Laboratory Medicine Volume 2, Issue 1, August 2025 Received: August 1, 2025, Reviewed: August 7,…
Nursing
October 1, 2024
A Multilayered Approach to Breaking the Cycle and Healing Intergenerational Trauma Through Maternal Wellness
Speaker Name: Ms. Humaira Nasim She will present her oral presentation at the 14th International Healthcare, Hospital Management, Nursing, and…
Healthcare
April 12, 2020
Novel Microwave Based Non-Invasive Glucose Device
Global Journal of Diabetes, Endocrinology & Metabolic Disorders Volume 1, Issue 1, June 2020, Pages: 12-20 Received: Mar. 17, 2020;…
Diabetes
September 8, 2022
Metabolic Markers of Drug Naive Type 2 Diabetes Patients of Bangladesh: Study in Tertiary Care Hospitals
Global Journal of Diabetes, Endocrinology & Metabolic Disorders Volume 1, Issue 1, September 2022, Pages: 22-33 Received: June 30, 2022,…
Pathology
September 13, 2025
A RARE CASE OF GENERALIZED PUSTULAR PSORIASIS
Keywords: Generalized pustular psoriasis, multisystem disease Introduction: Generalized pustular psoriasis (GPP) is a severe inflammatory dermatosis characterized by am eruption…
Cancer
February 27, 2024
KLK7 expression in human tumors: A tissue microarray study on 13,447 tumors
Presented in 13th Emirates Pathology, Digital Pathology & Cancer Conference Holiday Inn Dubai, UAE & Virtual Poster Presenter Name: Dr.…
Cancer
February 27, 2024
Upregulation of TIM3 and reduced expression of PD-1 on immune cell subsets in advanced prostate cancers
Presented in 13th Emirates Pathology, Digital Pathology & Cancer Conference Holiday Inn Dubai, UAE & Virtual Poster Presenter Name: Dr.…